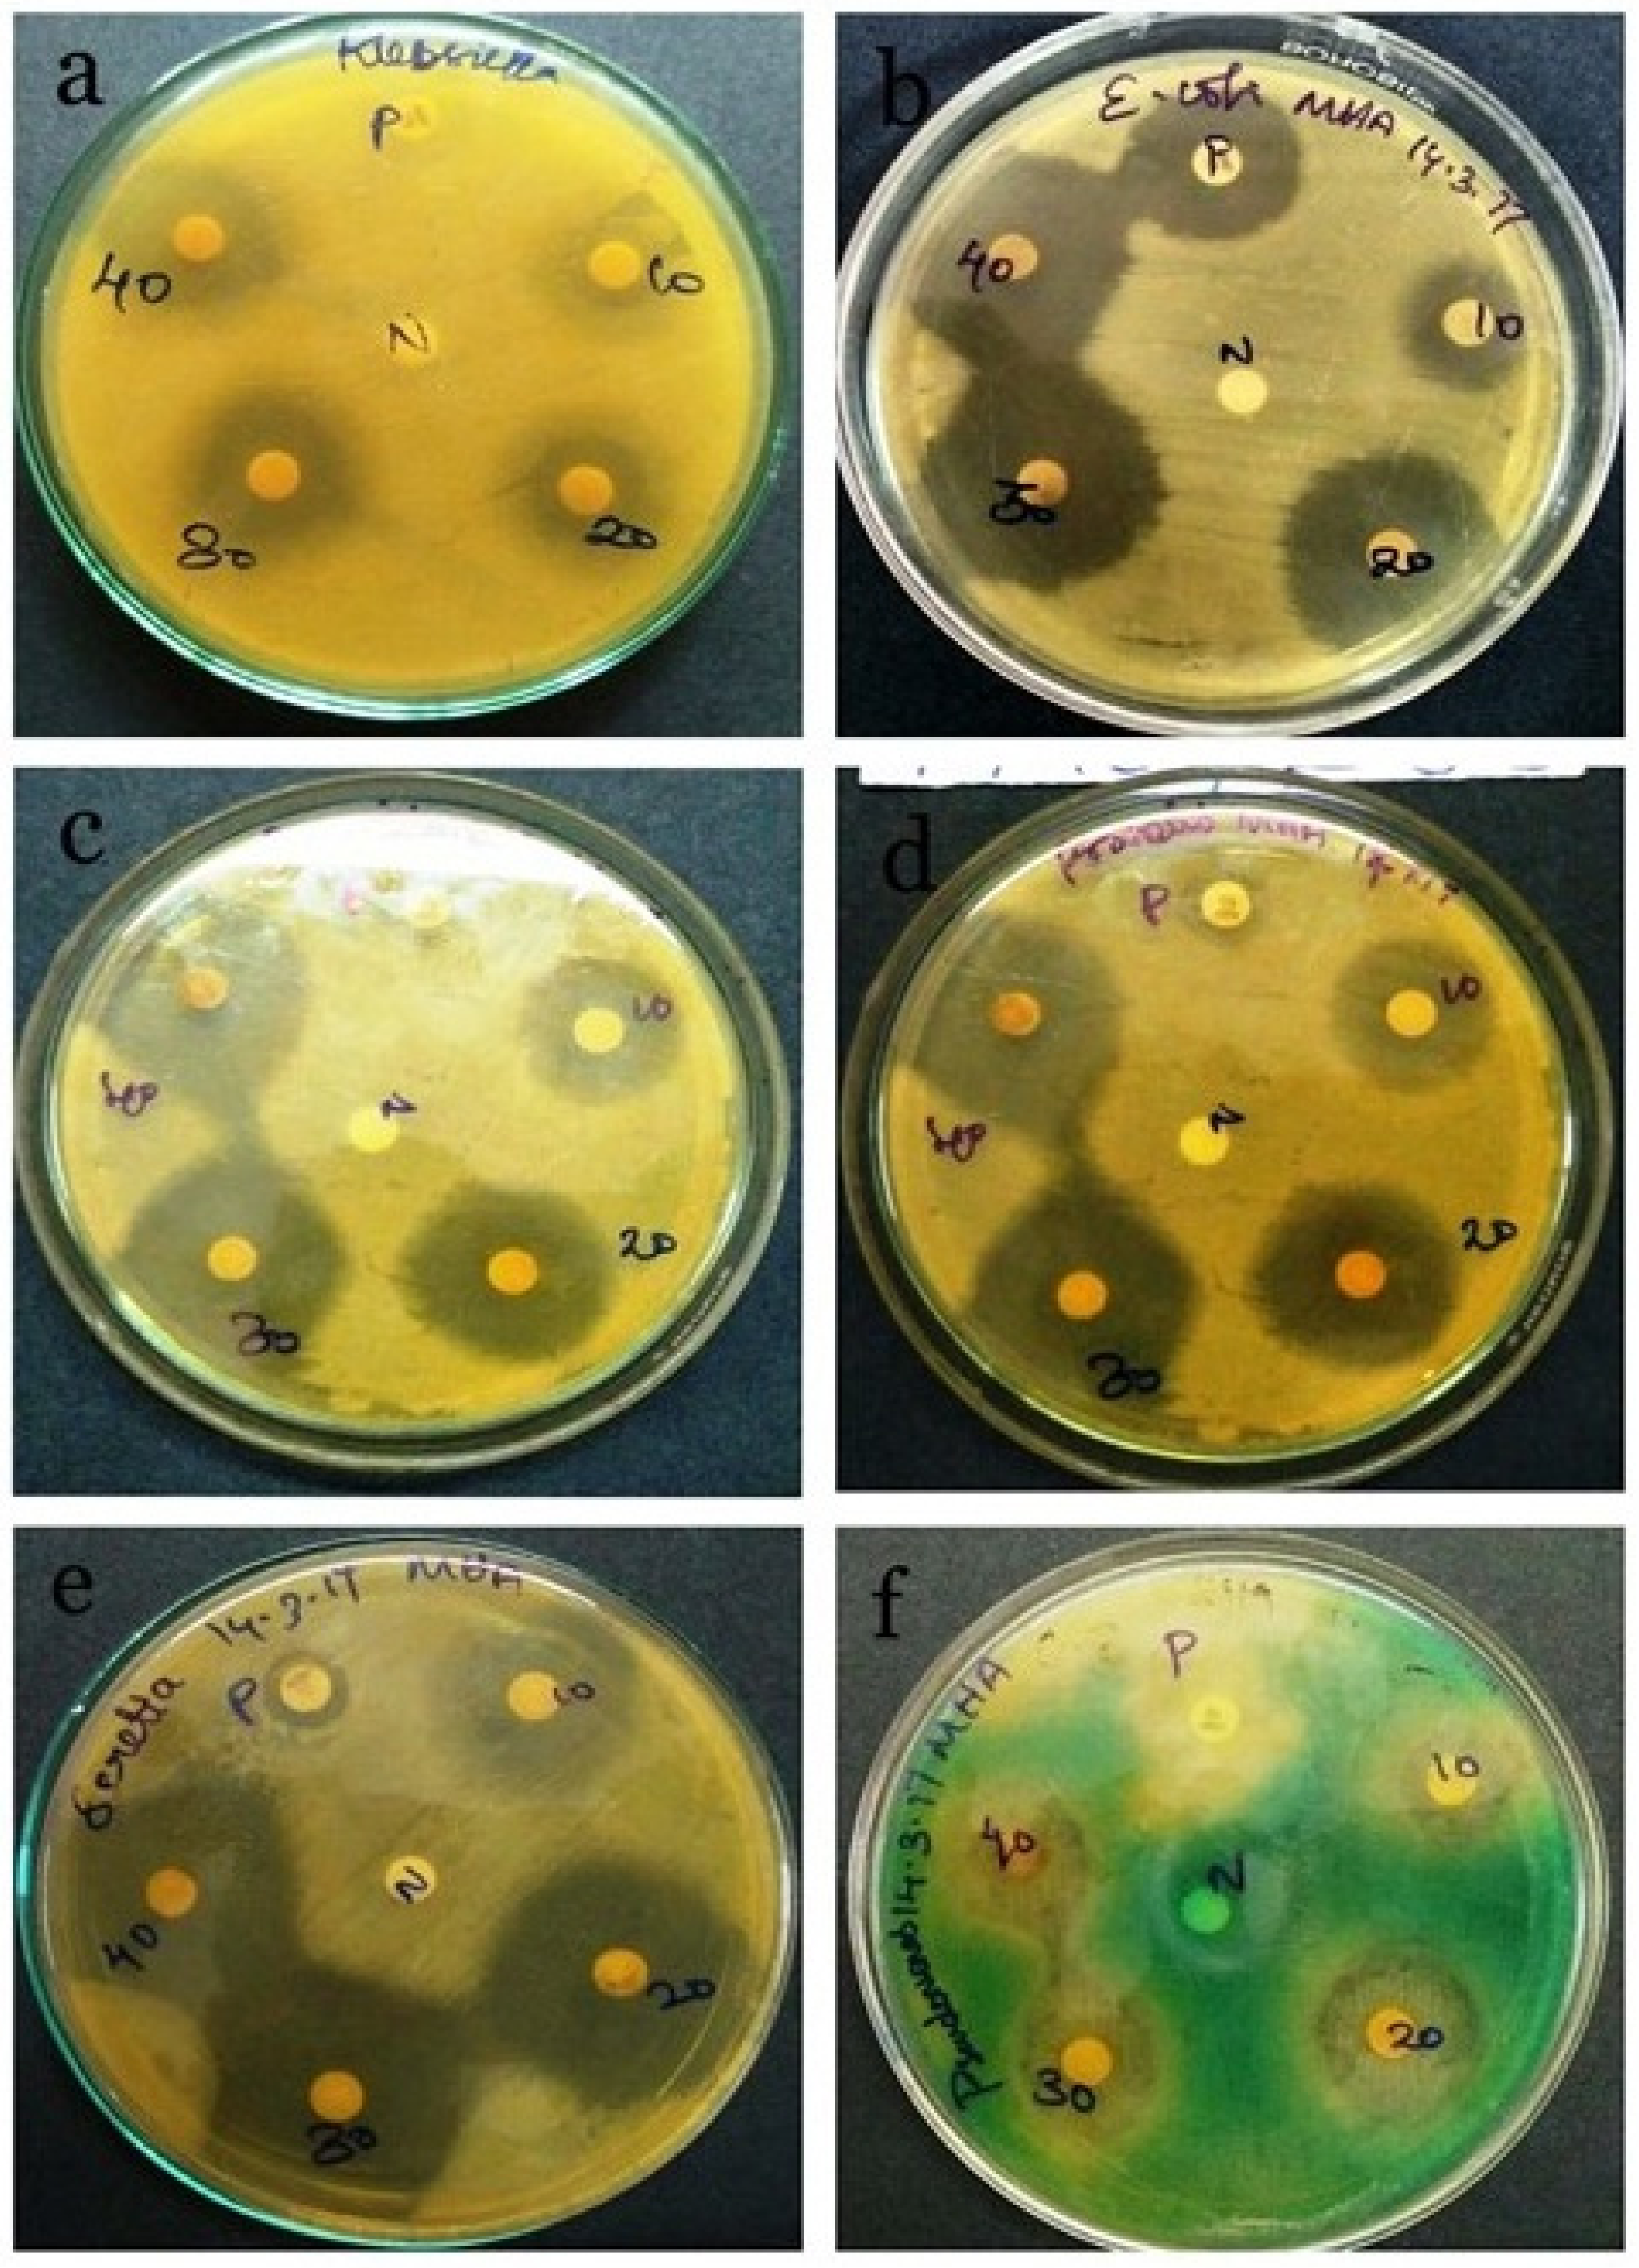

Prebiotic Potential and Value-Added Products Derived from Spirulina laxissima SV001—A Step towards Healthy Living
Abstract
1. Introduction
2. Materials and Methods
2.1. Study Area, Sample Collection and Isolation of Spirulina sp.
2.2. Medium for Maintaining and Harvesting Spirulina sp.
2.3. Morphological Studies
2.4. Molecular Identification of the Isolated Strain Using 16S rRNA
2.5. DNA Extraction
2.6. Primer Design and Polymerase Chain Reaction
2.7. Growth Parameters
2.7.1. Determination of Dry Biomass
2.7.2. Chlorophyll Estimation
2.7.3. Extraction of Phycocyanin
2.7.4. Estimation of Isolated Protein by Lowry’s Method
2.8. Antimicrobial and Antioxidant Activity of the Isolated Strain
2.8.1. Preparation of Aqueous Extract of Spirulina
2.8.2. Antibacterial Activity
2.8.3. Antioxidant Activity of Spirulina
2.8.4. Cytotoxic Activity of Spirulina
2.9. Value-Added Products of Spirulina
2.9.1. Spirulina Capsule
2.9.2. Spirulina Soap
2.9.3. Spirulina Chocolate
2.9.4. Spirulina Juice
2.9.5. Spirulina Tea
2.9.6. Spirulina Vermicelli
2.9.7. Spirulina Cake
2.10. Statistical Analysis
3. Results and Discussion
3.1. Study Area, Sample Collection and Cultivation of the Isolated Strain
3.2. Morphological and Molecular Identification
3.3. Biomass and Chlorophyll Content of Isolated Spirulina
3.4. Phycocyanin Concentration
3.5. Protein Estimation by the Lowry Method
3.6. Antibacterial Activity of Spirulina sp.
3.7. Antioxidant Activity of Spirulina
3.8. Cytotoxic Activity of Spirulina
3.9. Value-Added Products of Spirulina
4. Conclusions
Author Contributions
Funding
Institutional Review Board Statement
Informed Consent Statement
Data Availability Statement
Acknowledgments
Conflicts of Interest
References
- Adewuyi, A.O. Malnutrition and Its Impacts on the Rural Infants: An Example from Kuje Area Council, Federal Capital Territory-Nigeria. Soc. Sci. Learn. Educ. J. 2019, 4, 1–5. [Google Scholar]
- Skoet, J.; Stamoulis, K.G. The State of Food Insecurity in the World 2006: Eradicating World Hunger-Taking Stock Ten Years after the World Food Summit; Food & Agriculture Org.: Rome, Italy, 2006. [Google Scholar]
- World Health Organization. Turning the Tide of Malnutrition: Responding to the Challenge of the 21st Century; World Health Organization: Geneva, Switzerland, 2000. [Google Scholar]
- Hoseini, S.M.; Khosravi-Darani, K.; Mozafari, M.R. Nutritional and medical applications of Spirulina microalgae. Mini Rev. Med. Chem. 2013, 13, 1231–1237. [Google Scholar] [CrossRef] [PubMed]
- Yu, B. CFD Modeling of Two-Stage Parallel Plate Sedimentation Centrifuge for Microalgae Dewatering. 2012. Available online: http://citeseerx.ist.psu.edu/viewdoc/download?doi=10.1.1.838.190&rep=rep1&type=pdf (accessed on 18 April 2022).
- Vonshak, A. Spirulina: Growth, physiology and biochemistry. In Spirulina Platensis Arthrospira; CRC Press: Boca Raton, FL, USA, 1997; pp. 61–84. [Google Scholar]
- Aratboni, H.A.; Rafiei, N.; Garcia-Granados, R.; Alemzadeh, A.; Morones-Ramírez, J.R. Biomass and lipid induction strategies in microalgae for biofuel production and other applications. Microbial Cell Factories 2019, 18, 178. [Google Scholar] [CrossRef] [PubMed]
- Pandey, J.P.; Tiwari, A. Optimization of biomass production of Spirulina maxima. J. Algal. Biomass Utln. 2010, 1, 20–32. [Google Scholar]
- Khan, Z.; Bhadouria, P.; Bisen, P. Nutritional and therapeutic potential of Spirulina. Curr. Pharm. Biotechnol. 2005, 6, 373–379. [Google Scholar] [CrossRef] [PubMed]
- Ascaso, C. A rapid method for the quantitative isolation of green algae from lichens. Ann. Bot. 1980, 45, 483. [Google Scholar] [CrossRef]
- Yadav, A.; Dubey, K.; Parveen, S.; Rout, S.; Singh, D. Influence of BG-11 culture media on growth of Cyanobacteria, Oscillatoria Species. J. Appl. Sci. 2016, 2, 38–42. [Google Scholar]
- Jourdan, J.-P. Grow Your Own Spirulina; Antenna Technologies: Geneva, Switzerland, 2001. [Google Scholar]
- Ciferri, O. Spirulina, the edible microorganism. Microbiol. Rev. 1983, 47, 551–578. [Google Scholar] [CrossRef]
- Tomaselli, L. Morphology, ultrastructure and taxonomy of Arthrospira (Spirulina) maxima and Arthrospira (Spirulina) platensis. In Spirulina platensis (Arthrospira): Physiology, Cell-Biology and Biotechnology; CRC Press: Boca Raton, FL, USA, 1997; pp. 1–16. Available online: https://books.google.co.jp/books?hl=zh-CN&lr=&id=IKaKEqo6pB8C&oi=fnd&pg=PA1&dq=Morphology,+ultrastructure+and+taxonomy+of+Arthrospira+(Spirulina)+maxima+and+Arthrospira+(Spirulina)+platensis.&ots=zBp6o40bg_&sig=01Grs_-TabqexBpST6GpN1Pf-oM&redir_esc=y#v=onepage&q=Morphology%2C%20ultrastructure%20and%20taxonomy%20of%20Arthrospira%20(Spirulina)%20maxima%20and%20Arthrospira%20(Spirulina)%20platensis.&f=false (accessed on 18 April 2022).
- Woo, P.; Lau, S.; Teng, J.; Tse, H.; Yuen, K.-Y. Then and now: Use of 16S rDNA gene sequencing for bacterial identification and discovery of novel bacteria in clinical microbiology laboratories. Clin. Microbiol. Infect. 2008, 14, 908–934. Available online: https://www.sciencedirect.com/science/article/pii/S1198743X14610028 (accessed on 18 April 2022). [CrossRef]
- Pandey, J.; Pathak, N.; Tiwari, A. Standardization of pH and light intensity for the biomass production of Spirulina platensis. J. Algal. Biomass Utln. 2010, 1, 93–102. [Google Scholar]
- Mackinney, G. Absorption of light by chlorophyll solutions. J. Biol. Chem. 1941, 140, 315–322. Available online: https://www.sciencedirect.com/science/article/pii/S002192581851320X (accessed on 18 April 2022). [CrossRef]
- Bennett, A.; Bogorad, L. Complementary chromatic adaptation in a filamentous blue-green alga. J. Cell Biol. 1973, 58, 419–435. [Google Scholar] [CrossRef] [PubMed]
- Lowry, O.H.; Rosebrough, N.J.; Farr, A.L.; Randall, R.J. Protein measurement with the Folin phenol reagent. J. Biol. Chem. 1951, 193, 265–275. [Google Scholar] [CrossRef]
- Chu, W.-L.; Lim, Y.-W.; Radhakrishnan, A.K.; Lim, P.-E. Protective effect of aqueous extract from Spirulina platensis against cell death induced by free radicals. BMC Complement. Altern. Med. 2010, 10, 53. [Google Scholar] [CrossRef] [PubMed]
- Bayer, A.; Kirby, W.; Sherris, J.; Turck, M. Antibiotic susceptibility testing by a standardized single disc method. Am. J. Clin. Pathol. 1966, 45, 493–496. [Google Scholar] [CrossRef]
- Salmon, S.A.; Watts, J.L. Minimum inhibitory concentration determinations for various antimicrobial agents against 1570 bacterial isolates from turkey poults. Avian Dis. 2000, 44, 85–98. Available online: https://www.jstor.org/stable/1592511 (accessed on 18 April 2022). [CrossRef]
- Trojan, R.; Razdan, L.; Singh, N. Antibiotic susceptibility patterns of bacterial isolates from pus samples in a tertiary care hospital of Punjab, India. Int. J. Microbiol. 2016, 2016, 9302692. Available online: https://www.hindawi.com/journals/ijmicro/2016/9302692/ (accessed on 18 April 2022). [CrossRef]
- Choi, H.-S.; Song, H.S.; Ukeda, H.; Sawamura, M. Radical-scavenging activities of citrus essential oils and their components: Detection using 1, 1-diphenyl-2-picrylhydrazyl. J. Agric. Food Chem. 2000, 48, 4156–4161. [Google Scholar] [CrossRef]
- Yen, G.C.; Duh, P.D. Scavenging effect of methanolic extracts of peanut hulls on free-radical and active-oxygen species. J. Agric. Food Chem. 1994, 42, 629–632. [Google Scholar] [CrossRef]
- Parra, A.L.; Yhebra, R.S.; Sardiñas, I.G.; Buela, L.I. Comparative study of the assay of Artemia salina L. and the estimate of the medium lethal dose (LD50 value) in mice, to determine oral acute toxicity of plant extracts. Phytomedicine 2001, 8, 395–400. [Google Scholar]
- Sheath, R.G.; Wehr, J.D. Introduction to the Freshwater Algae. In Freshwater Algae of North America; Elsevier: Amsterdam, The Netherlands, 2015; pp. 1–11. [Google Scholar]
- Stoyneva, M.P.; Descy, J.-P. Cyanoprokaryote and algal biodiversity in the tropical Lake Edward (Africa) with notes on new, rare and potentially harmful species. Annu. Sofia Univ. Kliment Ohridski Fac. Biol. 2018, 102, 5–48. Available online: https://orbi.uliege.be/handle/2268/257520 (accessed on 18 April 2022).
- Gonçalves, A.L.; Pires, J.C.; Simoes, M. The effects of light and temperature on microalgal growth and nutrient removal: An experimental and mathematical approach. RSC Adv. 2016, 6, 22896–22907. [Google Scholar] [CrossRef]
- Danesi, E.D.G.; Rangel-Yagui, C.O.; Sato, S.; Carvalho, J.C.M. Growth and content of Spirulina platensis biomass chlorophyll cultivated at different values of light intensity and temperature using different nitrogen sources. Braz. J. Microbiol. 2011, 42, 362–373. [Google Scholar] [CrossRef] [PubMed]
- Pandey, J.; Tiwari, A.; Mishra, R. Evaluation of biomass production of Spirulina maxima on different reported media. J. Algal. Biomass Utln. 2010, 1, 70–81. [Google Scholar]
- Rodrigues, M.S.; Ferreira, L.S.; Converti, A.; Sato, S.; De Carvalho, J.C.M. Influence of ammonium sulphate feeding time on fed-batch Arthrospira (Spirulina) platensis cultivation and biomass composition with and without pH control. Bioresour. Technol. 2011, 102, 6587–6592. [Google Scholar] [CrossRef] [PubMed]
- Michael, A.; Kyewalyanga, M.S.; Lugomela, C.V. Biomass and nutritive value of Spirulina (Arthrospira fusiformis) cultivated in a cost-effective medium. Ann. Microbiol. 2019, 69, 1387–1395. Available online: https://link.springer.com/article/10.1007/s13213-019-01520-4 (accessed on 18 April 2022). [CrossRef]
- Marrez, D.A.; Naguib, M.M.; Sultan, Y.Y.; Daw, Z.Y.; Higazy, A.M. Evaluation of chemical composition for Spirulina platensis in different culture media. Res. J. Pharm. Biol. Chem. Sci. 2014, 5, 1161–1171. Available online: https://hero.epa.gov/hero/index.cfm/reference/details/reference_id/8345557 (accessed on 18 April 2022).
- Gitelson, A.A.; Laorawat, S.; Keydan, G.P.; Vonshak, A. Optical Properties of Dense Algal Cultures Outdoors and Their Application to Remote Estimation of Biomass and Pigment Concentration in Spirulina Platensis (cyanobacteria) 1. J. Phycol. 1995, 31, 828–834. Available online: https://onlinelibrary.wiley.com/doi/abs/10.1111/j.0022-3646.1995.00828.x (accessed on 18 April 2022). [CrossRef]
- Sharma, G.; Kumar, M.; Ali, M.I.; Jasuja, N.D. Effect of carbon content, salinity and pH on Spirulina platensis for phycocyanin, allophycocyanin and phycoerythrin accumulation. Microb. Biochem. Technol. 2014, 6, 202–206. [Google Scholar] [CrossRef]
- Tan, H.T.; Khong, N.M.; Khaw, Y.S.; Ahmad, S.A.; Yusoff, F.M. Optimization of the freezing-thawing method for extracting phycobiliproteins from Arthrospira sp. Molecules 2020, 25, 3894. Available online: https://www.mdpi.com/1420-3049/25/17/3894 (accessed on 18 April 2022). [CrossRef]
- Sivasankari, S.; Ravindran, D. Comparison of different extraction methods for phycocyanin extraction and yield from Spirulina platensis. Int. J. Curr. Microbiol. Appl. Sci. 2014, 3, 904–909. [Google Scholar]
- Morançais, M.; Mouget, J.-L.; Dumay, J. Proteins and pigments. Microalgae in Health and Disease Prevention; Elsevier: Amsterdam, The Netherlands, 2018; pp. 145–175. [Google Scholar] [CrossRef]
- Capelli, B.; Cysewski, G.R. Potential health benefits of Spirulina microalgae. Nutrafoods 2010, 9, 19–26. [Google Scholar] [CrossRef]
- Matufi, F.; Choopani, A. Spirulina, food of past, present and future. Health Biotechnol. Biopharma 2020, 3, 1–20. [Google Scholar]
- Pelizer, L.H.; Moraes, I.d.O. A method to estimate the biomass of Spirulina platensis cultivated on a solid medium. Braz. J. Microbiol. 2014, 45, 933–936. [Google Scholar] [CrossRef][Green Version]
- McCarty, M.F. Clinical potential of Spirulina as a source of phycocyanobilin. J. Med. Food 2007, 10, 566–570. [Google Scholar] [CrossRef]
- Soni, S.; Agrawal, K.; Srivastava, S.; Gupta, S.; Pankaj, C.K. Growth performance and biochemical analysis of Spirulina platensis under different culture conditions. J. Algal. Biomass Util. 2012, 3, 55–58. [Google Scholar]
- DiNicolantonio, J.J.; Bhat, A.G.; OKeefe, J. Effects of Spirulina on weight loss and blood lipids: A review. Open Heart 2020, 7, e001003. [Google Scholar] [CrossRef]
- Rafailidis, P.I.; Ioannidou, E.N.; Falagas, M.E. Ampicillin/sulbactam. Drugs 2007, 67, 1829–1849. [Google Scholar] [CrossRef]
- Peechakara, B.V.; Gupta, M. Ampicillin/sulbactam. In StatPearls; StatPearls Publishing: Treasure Island, FL, USA, 2021. Available online: https://www.ncbi.nlm.nih.gov/books/NBK526117/ (accessed on 18 April 2022).
- Sudha, S.; Karthic, R.; Naveen, J.R.; Rengaramanujam, J. Anti hyperlipidemic activity of Spirulina platensis in Triton X-100 induced hyperlipidemic rats. Hygeia J. Drugs Med. 2011, 3, 32–37. [Google Scholar]
- Elshouny, W.A.E.-F.; El-Sheekh, M.M.; Sabae, S.Z.; Khalil, M.A.; Badr, H.M. Antimicrobial activity of Spirulina platensis against aquatic bacterial isolates. J. Microbiol. Biotechnol. Food Sci. 2021, 2021, 1203–1208. [Google Scholar] [CrossRef]
- Usharani, G.; Srinivasan, G.; Sivasakthi, S.; Saranraj, P. Antimicrobial activity of Spirulina platensis solvent extracts against pathogenic bacteria and fungi. Adv. Biol. Res. 2015, 9, 292–298. [Google Scholar]
- Kuriakose, G.C.; Kurup, M.G. Antioxidant and antihepatotoxic effect of Spirulina laxissima against carbon tetrachloride induced hepatotoxicity in rats. Food Funct. 2011, 2, 190–196. [Google Scholar] [CrossRef] [PubMed]
- Miranda, M.; Cintra, R.; Barros, S.; Mancini-Filho, J. Antioxidant activity of the microalga Spirulina maxima. Braz. J. Med. Biol. Res. 1998, 31, 1075–1079. [Google Scholar] [CrossRef] [PubMed]
- Estrada, J.P.; Bescós, P.B.; Del Fresno, A.V. Antioxidant activity of different fractions of Spirulina platensis protean extract. Il Farmaco 2001, 56, 497–500. [Google Scholar] [CrossRef]
- Bashandy, S.A.; El Awdan, S.A.; Ebaid, H.; Alhazza, I.M. Antioxidant potential of Spirulina platensis mitigates oxidative stress and reprotoxicity induced by sodium arsenite in male rats. Oxidative Med. Cell. Longev. 2016, 2016, 7174351. [Google Scholar] [CrossRef]
- Harwig, J.; Scott, P. Brine shrimp (Artemia salina L.) larvae as a screening system for fungal toxins. Appl. Microbiol. 1971, 21, 1011–1016. [Google Scholar] [CrossRef]
- Gadir, S.A. Assessment of bioactivity of some Sudanese medicinal plants using brine shrimp (Artemia salina) lethality assay. J. Chem. Pharm. Res. 2012, 4, 5145–5148. [Google Scholar]
- Naidu, J.R.; Ismail, R.; Sasidharan, S. Acute oral toxicity and brine shrimp lethality of methanol extract of Mentha spicata L. (Lamiaceae). Trop. J. Pharm. Res. 2014, 13, 101–107. [Google Scholar] [CrossRef]
- Pisutthanan, S.; Plianbangchang, P.; Pisutthanan, N.; Ruanruay, S.; Muanrit, O. Brine shrimp lethality activity of Thai medicinal plants in the family Meliaceae. Naresuan Univ. J. Sci. Technol. 2013, 12, 13–18. [Google Scholar]
- Geran, R.; Greenberg, N.; Donald, M. Protocols for screening chemical agents and natural products against animal tumors and other biological systems. Cancer Chemother. Rep. 1972, 3, 1–103. [Google Scholar]
- Sahgal, G.; Ramanathan, S.; Sreenivasan Sasidharan, M.; Mordi, N.; Ismail, S.; Mansor, S.M. Brine shrimp lethality and acute oral toxicity studies on Swietenia mahagoni (Linn.) Jacq. seed methanolic extract. Pharmacogn. Res. 2010, 2, 215. [Google Scholar]

Publisher’s Note: MDPI stays neutral with regard to jurisdictional claims in published maps and institutional affiliations. |
© 2022 by the authors. Licensee MDPI, Basel, Switzerland. This article is an open access article distributed under the terms and conditions of the Creative Commons Attribution (CC BY) license (https://creativecommons.org/licenses/by/4.0/).
Share and Cite
Sankarapandian, V.; Nitharsan, K.; Parangusadoss, K.; Gangadaran, P.; Ramani, P.; Venmathi Maran, B.A.; Jogalekar, M.P. Prebiotic Potential and Value-Added Products Derived from Spirulina laxissima SV001—A Step towards Healthy Living. BioTech 2022, 11, 13. https://doi.org/10.3390/biotech11020013
Sankarapandian V, Nitharsan K, Parangusadoss K, Gangadaran P, Ramani P, Venmathi Maran BA, Jogalekar MP. Prebiotic Potential and Value-Added Products Derived from Spirulina laxissima SV001—A Step towards Healthy Living. BioTech. 2022; 11(2):13. https://doi.org/10.3390/biotech11020013
Chicago/Turabian StyleSankarapandian, Vidya, Kirubakaran Nitharsan, Kavitha Parangusadoss, Prakash Gangadaran, Prasanna Ramani, Balu Alagar Venmathi Maran, and Manasi P. Jogalekar. 2022. "Prebiotic Potential and Value-Added Products Derived from Spirulina laxissima SV001—A Step towards Healthy Living" BioTech 11, no. 2: 13. https://doi.org/10.3390/biotech11020013
APA StyleSankarapandian, V., Nitharsan, K., Parangusadoss, K., Gangadaran, P., Ramani, P., Venmathi Maran, B. A., & Jogalekar, M. P. (2022). Prebiotic Potential and Value-Added Products Derived from Spirulina laxissima SV001—A Step towards Healthy Living. BioTech, 11(2), 13. https://doi.org/10.3390/biotech11020013

